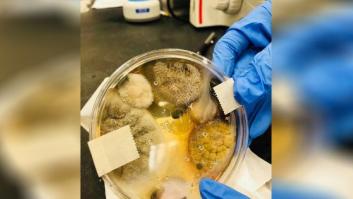
¿Secamanos eléctrico o papel? Esta atroz foto de bacterias reabre el debate

bacterias
bacterias


Amputado por los lametazos de un perro
El estadounidense Greg Manteufel, de 48 años, ha perdido los brazos, las piernas y parte de la nariz por una infección en la sangre.

Cómo los móviles nos están dañando la piel, según los dermatólogos
Quizá no te lo habías planteado.

Todo lo que debes saber sobre las bacterias de tu vagina
No son tan malas como piensas.

¿Hace falta ducharse todos los días?
Tenemos sobre nuestra piel entre 100 y un millón de bacterias por centímetro cuadrado.
¿Secamanos eléctrico o papel? Esta atroz foto de bacterias reabre el debate
Esta imagen te va a dar escalofríos.


Las moscas transportan muchas más bacterias y enfermedades de las que se creía
Estos molestos bichos alados se reproducen y viven en heces y en cadáveres en descomposición.

Cuatro consejos para evitar el riesgo de intoxicación al usar bolsas reutilizables
Ante todo, organización y limpieza.

Hay una ingente (y desconocida) cantidad de gérmenes en las salidas de aire del avión
Vale, quizá no llamen tanto la atención como las bandejas, las mantas o los baños, pero todo el mundo las toquetea sin parar.

Por qué quitarte los zapatos al entrar a casa es lo mejor que puedes hacer
El calzado hace que introduzcamos más de 440.000 bacterias en nuestro hogar.







Bacterias marinas de turno de mañana y turno de tarde
Todos los seres vivos tienen hábitos y rutina. Se encuentra desde el hombre hasta otros mamíferos e incluso en los insectos. Lo que se desconocía hasta ahora es la existencia de conductas rutinarias en seres con una gran simplicidad, como las bacterias.







